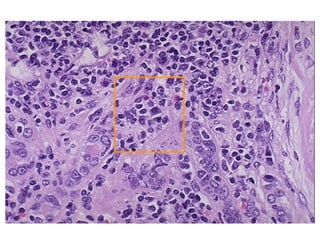

This document provides an overview of tubular diseases and pathologies of the kidney. It discusses acute tubular necrosis, tubulointerstitial nephritis including pyelonephritis, drug and toxin induced interstitial nephritis, urate nephropathy, hypercalcemia, multiple myeloma, and vascular diseases of the kidney. It describes the pathogenesis, clinical presentation, morphology, and factors involved in various acute and chronic kidney diseases that impact the tubules, interstitium, and blood vessels of the kidney.